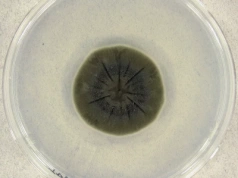
Grzyb z Czarnobyla żywi się śmiertelnym promieniowaniem. To przepustka do podróży w kosmos?

W kieleckich kawiarniach i biurach łatwo zauważyć ludzi, którzy po całym dniu pracy otwierają laptop, żeby przejrzeć materiały do zajęć. Notatki leżą obok kubka z herbatą, w tle dzwoni służbowy telefon, a ktoś jeszcze próbuje zdążyć na wykład online. W ich twarzach widać to samo napięcie: zmęczenie...
Ilość odsłon: 2
źródło: https://radiokielce.pl/1362936/kiedy-studia-staja-sie-przepustka-do-zmiany-zawodu-dlaczego-dorosli-wracaja-do-nauki/
dodano: 2025-12-03 01:03:30
Inne znaleziska:
Grzyb z Czarnobyla żywi się śmiertelnym promieniowaniem. To przepustka do podróży w kosmos?
Grzyb z Czarnobyla żywi się śmiertelnym promieniowaniem. To przepustka do podróży w kosmos?
Grzyby znalezione w Czarnobylu mają zdolność do pochłaniania promieniowania, również kosmicznego. Może to stanowić ochronę dla astronautów podczas podróży kosmicznych.
wprost.pl,
2025-12-03 08:35:06
2025-12-03 08:35:06
Lekkoatletyka: Rekord życiowy Wegnera przepustką do finału MŚ!
Lekkoatletyka: Rekord życiowy Wegnera przepustką do finału MŚ!
Dawid Wegner pobił swój rekord życiowy w ostatniej próbie eliminacji, dzięki której wywalczył awans do finału Mistrzostw Świata. W środę na Stadionie Narodowym w Tokio mogliśmy śledzić tylko jedną konkurencję z udziałem Biało-Czerwonych. Były to elim...
sbcportalsportowy.pl,
2025-09-17 15:41:17
2025-09-17 15:41:17
Nasze dziewczyny najlepsze na Dolnym Śląsku i z przepustką na PGE Narodowy!
Nasze dziewczyny najlepsze na Dolnym Śląsku i z przepustką na PGE Narodowy!
Drużyna dziewcząt ze Szkoły Podstawowej nr 4 w Świdnicy odniosła ogromny sukces, wygrywając finał wojewódzki turnieju „Z Orlika na Stadion” w kategorii U-15. Dzięki temu zwycięstwu świdnickie zawodniczki awansowały do finału ogólnopolskiego, który od...
swidnica24.pl,
2025-10-27 00:13:09
2025-10-27 00:13:09
Prawo Fergusona: kiedy odsetki stają się groźniejsze od wrogów
Prawo Fergusona: kiedy odsetki stają się groźniejsze od wrogów
Czy istnieją finansowe uwarunkowania upadku mocarstw? Historia sugeruje, że tak. Można je ująć w prostą zasadę – „prawo Fergusona”: każde mocarstwo, które wydaje więcej na obsługę długu niż na obronę, ryzykuje, iż przestanie być mocarstwem. The post...
obserwatorfinansowy.pl,
2025-11-21 06:49:12
2025-11-21 06:49:12
Nowoczesność zaczyna się tu i teraz. Sprawdź, jak Europejskie Centra Innowacji Cyfrowych stają się k...
Nowoczesność zaczyna się tu i teraz. Sprawdź, jak Europejskie Centra Innowacji Cyfrowych stają się kluczem do przemiany i sukcesu lokalnego biznesu
Polskie firmy często wstrzymują się z wdrażaniem nowoczesnych technologii z obawy przed kosztami, skomplikowanymi procesami czy brakiem wiedzy. Tymczasem mali i średni przedsiębiorcy mają możliwość skorzystania z bezpłatnej pomocy Europejskich Centró...
gazeta.pl,
2025-07-25 10:24:08
2025-07-25 10:24:08
Przyspieszają zmiany na globalnym rynku drobiarskim - niedawni importerzy stają się znaczącymi ekspo...
Przyspieszają zmiany na globalnym rynku drobiarskim - niedawni importerzy stają się znaczącymi eksporterami
Zmiany na globalnym rynku mięsa drobiowego następują coraz szybciej. Kraje, a nawet całe kontynenty, które jeszcze niedawno zmagały się z importem mięsa drobiowego, stają się znaczącymi producentami i eksporterami drobiu.
cenyrolnicze.pl,
2025-07-18 15:39:07
2025-07-18 15:39:07
Indeksy z Wall Street stają się przewartościowane? Duży bank ostrzega
Indeksy z Wall Street stają się przewartościowane? Duży bank ostrzega
Notowania amerykańskich indeksów giełdowych biją kolejne historyczne szczyty, a inwestorzy wpadają w euforię. Najnowszy raport Bank of America wskazuje jednak, że zarządzający funduszami są dziś bardziej byczo nastawieni, niż przez ostatnie lata, co...
comparic.pl,
2025-07-21 13:59:06
2025-07-21 13:59:06
Polacy stają się płaskoziemcami. Może i wierzą w dinozaury, ale już nie w ewolucję
Polacy stają się płaskoziemcami. Może i wierzą w dinozaury, ale już nie w ewolucję
Nie dość, że jesteśmy analfabetami funkcjonalnymi, bo literki wprawdzie składać w słowa umiemy, ale nie potrafimy czytać ze zrozumieniem instrukcji obsługi pralki, to jeszcze wierzymy w teorie spiskowe. Za to nie wierzymy naukowcom. Najnowszy raport...
natemat.pl,
2025-07-22 05:44:08
2025-07-22 05:44:08
W dobie automatyzacji i coraz potężniejszych technologii piechota nie pójdzie w odstawkę, a wyewoluuje. Chiny po cichu budują nowy typ żołnierza. Jednak nie takiego żołnierza, który tylko walczy, ale takiego, który kalkuluje, widzi przez ściany, wyst...
chip.pl,
2025-07-27 06:31:21
2025-07-27 06:31:21
Chorwaci zachwyceni polskimi turystami. "Portfele Polaków stają się coraz grubsze"
Chorwaci zachwyceni polskimi turystami. "Portfele Polaków stają się coraz grubsze"
Czy Chorwacja jest dobrym miejscem na urlop? Mimo rosnących cen w sezonie wakacyjnym Polacy tłumnie zawitali nad Adriatyk. Liczba polskich turystów stale rośnie, chociaż wymagania i zasobność naszych portfeli uległa zmianie.
gazeta.pl,
2025-08-19 11:41:02
2025-08-19 11:41:02